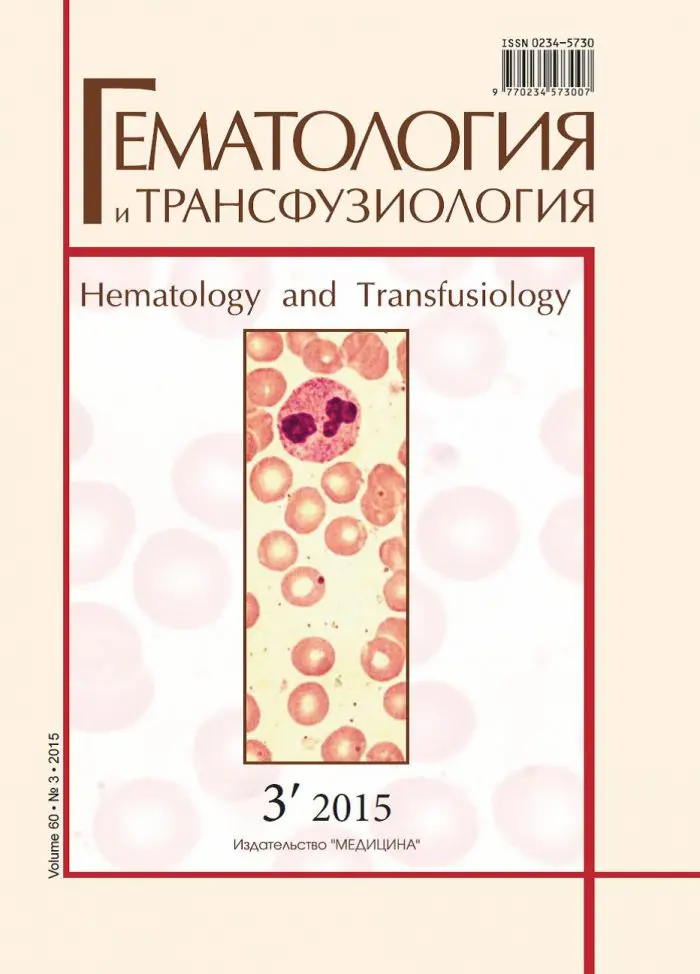

Гематология и трансфузиология
Br 127.00 за 6 месяцев с НДС
Журнал адресован гематологам, научным сотрудникам, трансфузиологам, работникам службы крови, врачам-лаборантам, терапевтам, хирургам, педиатрам, анестезиологам, реаниматологам, а также физиологам, патофизиологам, патологам и другим представителям теоретических дисциплин и всем врачам, интересующимся вопросами переливания крови и патологии системы крови.
Журнал адресован гематологам, научным сотрудникам, трансфузиологам, работникам службы крови, врачам-лаборантам, терапевтам, хирургам, педиатрам, анестезиологам, реаниматологам, а также физиологам, патофизиологам, патологам и другим представителям теоретических дисциплин и всем врачам, интересующимся вопросами переливания крови и патологии системы крови.
| release |
2 |
|---|
MAECENAS IACULIS
Vestibulum curae torquent diam diam commodo parturient penatibus nunc dui adipiscing convallis bulum parturient suspendisse parturient a.Parturient in parturient scelerisque nibh lectus quam a natoque adipiscing a vestibulum hendrerit et pharetra fames nunc natoque dui.
ADIPISCING CONVALLIS BULUM
- Vestibulum penatibus nunc dui adipiscing convallis bulum parturient suspendisse.
- Abitur parturient praesent lectus quam a natoque adipiscing a vestibulum hendre.
- Diam parturient dictumst parturient scelerisque nibh lectus.
Scelerisque adipiscing bibendum sem vestibulum et in a a a purus lectus faucibus lobortis tincidunt purus lectus nisl class eros.Condimentum a et ullamcorper dictumst mus et tristique elementum nam inceptos hac parturient scelerisque vestibulum amet elit ut volutpat.